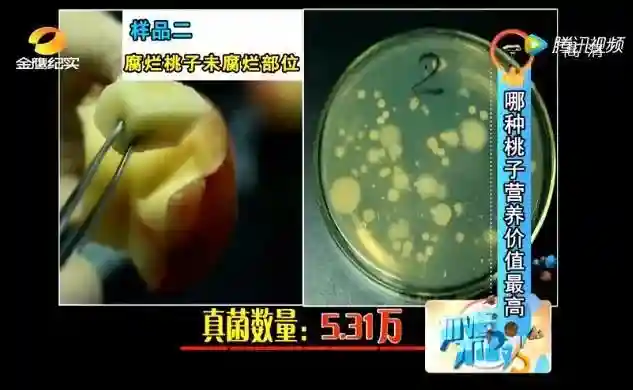

烂了一部分的水果,
你会选择怎么办?
年轻人也许会直接丢掉,
但勤俭节约惯了的爸妈和长辈们,
却常常会舍不得扔,
把烂了的部分切掉,把剩下的部分吃了。
那么,这种做法到底对吗?

发霉的水果不论大小
都可能含有多种真菌毒素
首先要了解一下水果容易霉烂的原因。
其实任何食物表面都围绕着一群饥渴的微生物,常见的就是霉菌,水果的发霉腐烂,主要就由它而起。
大部分水果都是汁多糖多营养多,非常适合霉菌拿来养育下一代。只要有机会,霉菌就能立刻入侵果肉并大量繁殖,造成腐烂。

不同形式不同程度花式腐烂的橘子
霉菌其实是一个大家族,一般的霉菌,吃下去也不会怎么样,但有不少霉菌在适合的条件下,会产生非常危险的毒素。
水果中常见且值得担心的真菌毒素有2种:
展青霉产生的展青霉素(Patulin,PAT)
赭曲霉毒素A(OchratoxinA,OTA)
这2种毒素明确有害健康,国际癌症研究机构(IARC)分别将PAT、OTA列为3类、2B类致癌物。
不过这两种毒素属于「可能致癌物」,致癌的危害性不是太高。像2B类致癌物,是「可能性较低」的致癌物质,3类致癌物,是「尚不能分类」的致癌物质,人群研究证据不足,暂时不用太担心。
可能有的人会问了,只要是烂掉的水果,都有这些毒素吗?
还真是,因为这两种毒素污染的水果都挺常见的。

切掉坏的部分吃剩下的?
其实是在赌运气
切掉水果腐烂的部分,剩下的继续吃,其实这样风险不小:



红圈内的棕褐色部分,是果肉的「内部腐烂」
可能有人会抱有侥幸心理,削掉坏的剩下的部分,是不是真菌就没有那么多?
还真不是这样,因为真菌会在烂水果的果肉内蔓延。
有电视台曾做过一档科普栏目,大家看看就能感受到真菌(霉菌)是一群怎样的「流动人口」。
节目组找了一个腐烂桃子和一个新鲜桃子,分别取样,检测真菌数量。

检测腐烂部分的桃子,真菌数量8.25万。

检测同一个桃子未腐烂部分,真菌数量5.31万。
检测新鲜桃子,真菌数量8千。

很显然,只要桃子发生腐烂,即便是好的那部分,真菌数量比新鲜桃子提升了很多倍。
其实可以理解为,一旦水果腐烂,就算切掉烂的,剩下的部分仍然是「歪瓜裂枣」。
水果,烂了就扔掉
少数食物,切掉烂的部分还能吃
我们已经知道,一些常见霉菌在适宜条件下会产生致癌毒素,而只要极少的致癌毒素就对人有害,这也就意味着,致癌物其实是没有安全剂量的。
所以,只要是发霉腐烂长绿毛的水果,不管贵不贵,扔掉也不心疼。
但肯定有些长辈会问,丢了太可惜,是不是所有食物都要扔掉?
如果实在舍不得扔,美国农业部(USDA)提供一个解决方案,大致原则是:
软质的食物,含水量多霉菌蔓延快,扔掉;
硬质的食物,霉菌一般难以在内部蔓延,可以切掉长霉的部分,剩下的继续吃。
常见的食物及处理方式,都在这张表里了:

其实长辈们已经习惯勤俭持家,这完全可以理解。但为了省几个水果的小钱,冒着生病致癌的风险,实在不值得。
尤其是很多长辈没有意识到,在不知不觉中习惯吃坏掉的水果,哪怕切掉烂的部分,并不能阻止「烂从口入」……
为了家人的安全和健康,
一定记得提醒他们!

●有颜值有胆识!余杭这位美女一袭红衣,直面生死!她的“壮举”让人动容|余杭生活家
●适合亲子出游的余杭民宿大盘点!暑假可以带娃约起来了~
●与杭州中环相接!望梅高架路二期工程开工,计划2022年7月底前完工
内容支持/丁香医生
编辑/一聪
